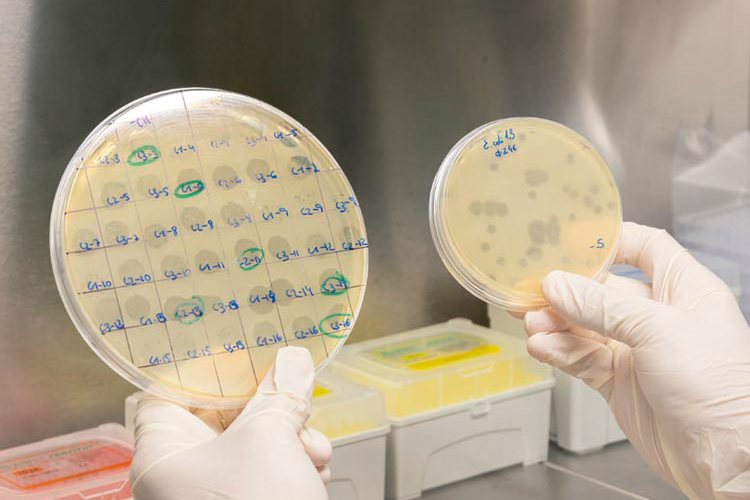
bacteriofagos_control_Salmonella-

El chip microfluídico de la UAB: más detección, menos vueltas
En sanidad animal, muchas decisiones empiezan con una pregunta sencilla: ¿qué patógenos están presentes en esta muestra? El reto llega cuando la lista de posibles… Read More »El chip microfluídico de la UAB: más detección, menos vueltas